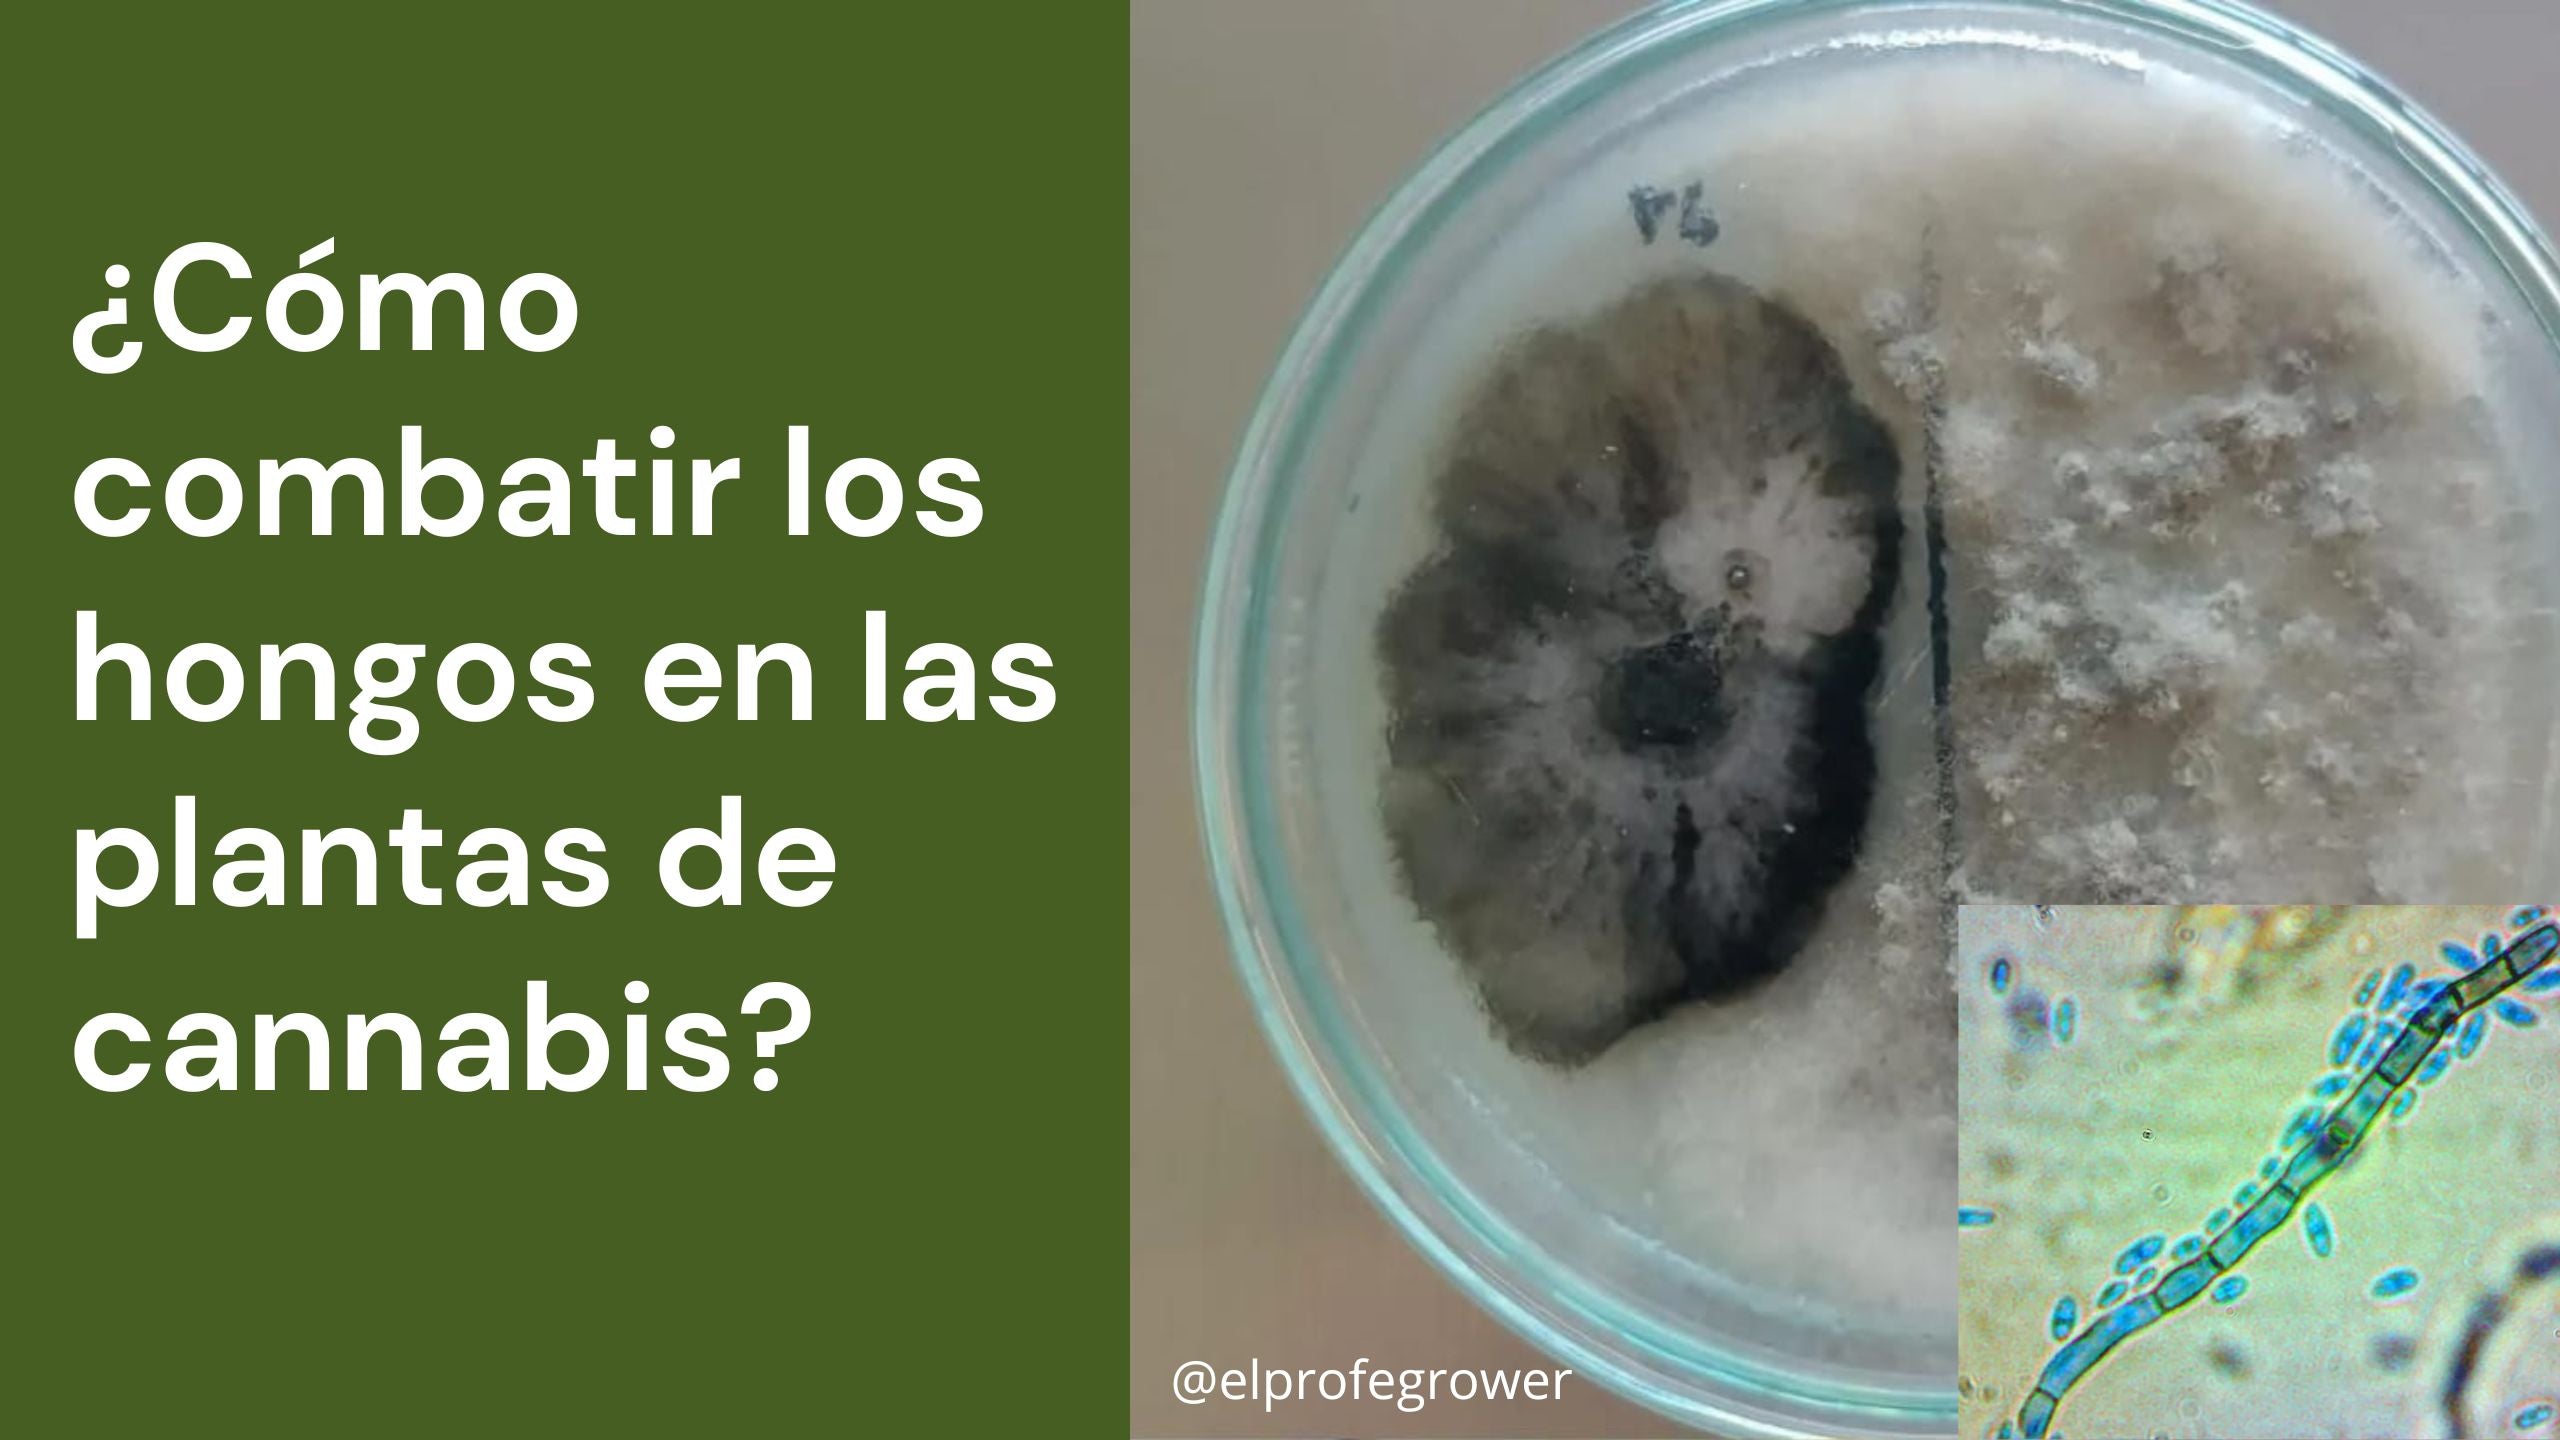

Aprende a cultivar (Blog)
Protocolo para el Control y Prevención de Mosca Blanca y Mosca de Mantillo
Protocolo para el control y prevención de Fusarium
Hermafroditismo en el cannabis

¿Cuánto THC tiene el cannabis? Conoce los niveles y cómo se miden

Fotoperiodo invertido y personalizado: Cómo mejorar la temperatura en el cultivo
¿Cómo combatir los hongos en las plantas de cannabis?

Qué son semillas Feminizadas, Autoflorecientes y Regulares

FOTOPERIODO. Floración forzada en cannabis

Cómo sembrar semillas germinadas de cannabis

Cómo germinar semillas de cannabis Método de germinación Z (Profe Daniel)
